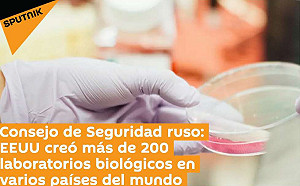

發布 2020.07.20 16:11
新聞跑馬燈
最新報導
-
 留言
留言 -
 留言
留言發布 2020.07.20 16:11
許章潤被囚獲釋後不改大砲本色 澳學者:在中國 順我者昌逆我者「嫖娼」
-

PR
在「光明之地」被世界看見 雲林榮獲ICF 2026 全球Top7智慧城市
-
 留言
留言發布 2020.07.20 16:10
台北市十大死因出爐!肺癌連34年居冠
-
 留言
留言發布 2020.07.20 15:59
日本補助87家日企撤離中國 大手筆砸近2百億
-
 留言
留言發布 2020.07.20 15:58
中國稱美實驗室洩漏病毒 釀成不明肺炎在哈薩克流行
-
 留言
留言發布 2020.07.20 15:55
花蓮百年廟宇換新裝!賞炫目光雕秀玩AR互動遊戲
-
 留言
留言發布 2020.07.20 15:53
神邏輯!董事長樂團林大鈞 怒揭三倍「騙局」說關鍵
-
 留言
留言發布 2020.07.20 15:51
美聲齊放!8/1花蓮天祥賞最「原汁原味」傳統歌舞樂曲
-
 留言
留言發布 2020.07.20 15:43
盧秀燕送潭子人驚喜大禮 新闢道路竟捨直取彎?議員要求打掉重做
-
 留言
留言發布 2020.07.20 15:42
國民黨團批假三倍券流入市面 籲檢警展開調查
-
 留言
留言發布 2020.07.20 15:40
陪審、參審兩制併行? 柯建銘吐槽:全世界首創拼裝車
-
 留言
留言發布 2020.07.20 15:40
傅高義 : 美中可能發生災難性戰爭 台灣將是導火線
-
 留言
留言發布 2020.07.20 15:39
英擬中止對香港引渡協議 中國大使嗆「不要隨美國起舞」
-
 留言
留言發布 2020.07.20 15:36
華盛頓特區發生槍擊案 一死八傷
-
 留言
留言發布 2020.07.20 15:24
動滋網進得去了!動滋券登記首日已有12萬人註冊成功
-
 留言
留言發布 2020.07.20 15:20
來台中消費有機會抽中名畫 9月12日抽出幸運得主
-
 留言
留言發布 2020.07.20 15:13
認定中國疫情風險低於日本 台大籲政府儘速開放中生入境
-
 留言
留言發布 2020.07.20 15:10
無視七成民眾贊成延期或取消 東奧組委會:不可能取消
-
 留言
留言發布 2020.07.20 15:08
蘇嘉全:2017年1整年沒去印尼 將提告捍衛清白
-
 留言
留言發布 2020.07.20 15:06
率性又俐落! 韓國新廉航Aero K推出帥氣「無性別制服」